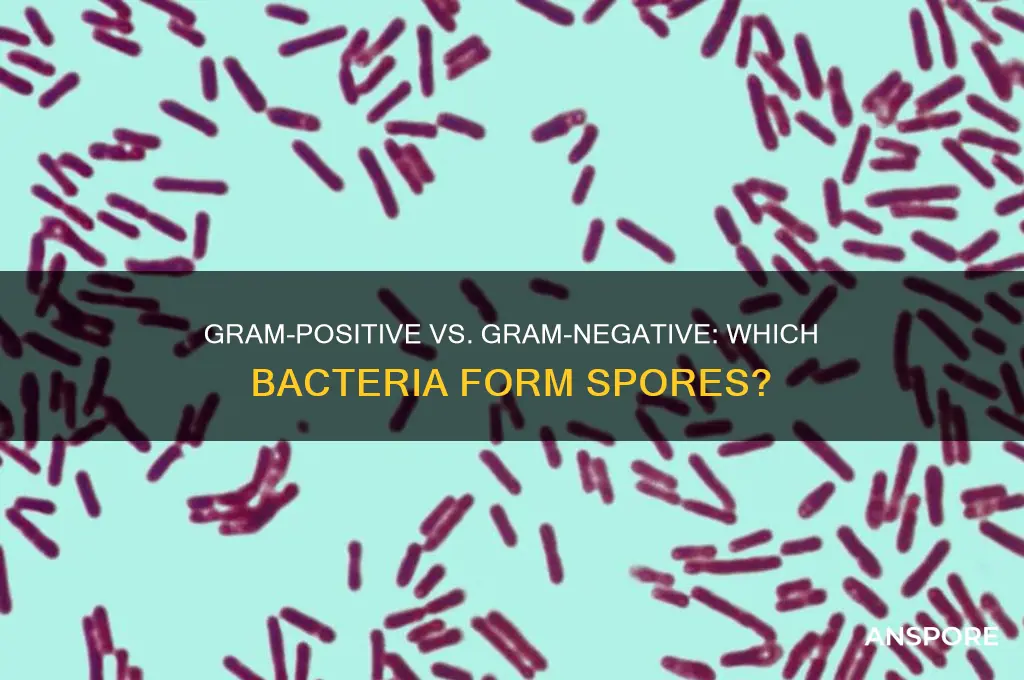
do gram positive or gram negative have spores

The question of whether Gram-positive or Gram-negative bacteria form spores is a fundamental distinction in microbiology. Gram-positive bacteria, characterized by their thick peptidoglycan cell wall, are well-known for their ability to produce endospores, highly resistant structures that allow them to survive harsh environmental conditions. Notable examples include *Bacillus* and *Clostridium* species. In contrast, Gram-negative bacteria, with their thinner peptidoglycan layer and additional outer membrane, generally do not form spores, relying instead on other mechanisms for survival. While exceptions exist, such as *Sporomusa* in rare cases, the ability to sporulate is predominantly a trait of Gram-positive bacteria, highlighting a key difference in their adaptive strategies.
| Characteristics | Values |
|---|---|
| Gram-Positive Bacteria Spores | Many gram-positive bacteria (e.g., Bacillus, Clostridium) form spores. |
| Gram-Negative Bacteria Spores | Most gram-negative bacteria do not form spores, with rare exceptions (e.g., Adenosynbacter). |
| Spore Formation Mechanism | Sporulation is a survival mechanism in harsh conditions (e.g., heat, desiccation). |
| Spore Structure | Spores have a thick, protective coat and are highly resistant to environmental stresses. |
| Gram-Positive Spore Examples | Bacillus anthracis, Clostridium botulinum, Sporosarcina. |
| Gram-Negative Spore Examples | Adenosynbacter (rare case), Oceanobacillus (debated classification). |
| Prevalence of Spore Formation | Common in gram-positive bacteria, uncommon in gram-negative bacteria. |
| Clinical Significance | Spores can cause infections (e.g., anthrax) and food spoilage. |
| Staining Properties | Spores stain differently (e.g., with malachite green) due to their unique structure. |
| Environmental Resistance | Spores can survive extreme conditions for years, unlike vegetative cells. |
Explore related products
What You'll Learn
- Spore Formation Mechanisms: Gram-positive bacteria primarily form spores; Gram-negative rarely do
- Environmental Survival: Spores aid Gram-positive survival in harsh conditions; Gram-negative rely on other strategies
- Species Examples: *Bacillus* (Gram-positive) vs. *E. coli* (Gram-negative) spore capabilities
- Cell Wall Structure: Thick peptidoglycan in Gram-positive supports spore development; Gram-negative lacks this
- Clinical Implications: Spores in Gram-positive increase antibiotic resistance; Gram-negative less affected by spores

Spore Formation Mechanisms: Gram-positive bacteria primarily form spores; Gram-negative rarely do
Gram-positive bacteria are renowned for their ability to form highly resistant spores, a survival mechanism that allows them to endure extreme conditions such as heat, desiccation, and radiation. This process, known as sporulation, is a complex, multi-stage transformation where a vegetative cell differentiates into a spore. For instance, *Bacillus subtilis* and *Clostridium botulinum* are classic examples of Gram-positive bacteria that sporulate. In contrast, Gram-negative bacteria rarely form spores, with only a few exceptions like *Adenosynbacter* and *Oceanibacillus*. This disparity raises questions about the evolutionary and structural differences between these bacterial groups.
The mechanism of spore formation in Gram-positive bacteria involves a series of tightly regulated genetic and morphological changes. It begins with the activation of the *spo0A* gene, which triggers the asymmetric division of the cell into a larger mother cell and a smaller forespore. The mother cell then engulfs the forespore, and multiple protective layers, including the cortex, coat, and exosporium, are synthesized. These layers provide the spore with its remarkable durability. For example, *Bacillus* spores can survive boiling temperatures for extended periods, a trait exploited in food sterilization processes. Understanding this mechanism is crucial for industries like food safety and medicine, where spore-forming pathogens pose significant challenges.
From a practical standpoint, the rarity of spore formation in Gram-negative bacteria is linked to their distinct cell wall structure. Gram-negative bacteria have a thin peptidoglycan layer surrounded by an outer membrane, which complicates the sporulation process. Sporulation requires significant cellular reorganization, and the outer membrane may hinder the formation of the protective layers necessary for spore viability. Exceptions like *Adenosynbacter* suggest that sporulation in Gram-negative bacteria may involve unique adaptations, but these cases are rare and not well understood. This structural difference underscores why Gram-positive bacteria dominate the sporulating landscape.
For researchers and practitioners, distinguishing between spore-forming and non-spore-forming bacteria is essential for effective control strategies. For instance, in healthcare settings, Gram-positive spores like those of *Clostridioides difficile* require stringent disinfection protocols, often involving spore-specific agents like chlorine bleach. In contrast, Gram-negative bacteria, even in their vegetative state, are typically more susceptible to common disinfectants due to their outer membrane’s vulnerability. Knowing which group forms spores can guide the selection of appropriate sterilization methods, ensuring safety in clinical, industrial, and environmental contexts.
In conclusion, the disparity in spore formation between Gram-positive and Gram-negative bacteria highlights the intricate relationship between bacterial structure and survival strategies. While Gram-positive bacteria have evolved robust mechanisms to produce resilient spores, Gram-negative bacteria’s structural constraints limit their ability to do so. This knowledge not only deepens our understanding of bacterial biology but also informs practical applications in fields ranging from microbiology to public health. By focusing on these mechanisms, we can develop more targeted and effective strategies to manage bacterial threats.
Dandelions: Seeds or Spores? Unraveling the Mystery of Their Reproduction
You may want to see also

Environmental Survival: Spores aid Gram-positive survival in harsh conditions; Gram-negative rely on other strategies
Spores are a hallmark of certain Gram-positive bacteria, providing them with a remarkable ability to withstand extreme environmental conditions. These dormant, highly resistant structures allow bacteria like *Clostridium botulinum* and *Bacillus anthracis* to survive desiccation, heat, and chemical exposure for years. In contrast, Gram-negative bacteria lack this spore-forming capability, relying instead on other mechanisms to endure harsh environments. This fundamental difference in survival strategies highlights the evolutionary adaptations of these two bacterial groups.
To understand the advantage spores confer, consider their structure. A spore consists of a thick, multilayered coat surrounding dehydrated DNA and essential enzymes. This design minimizes water content and protects genetic material from damage. For instance, *Bacillus subtilis* spores can survive temperatures exceeding 100°C for hours, a feat unachievable by most Gram-negative bacteria. In practical terms, this means Gram-positive spores can persist in soil, dust, and even processed foods, posing challenges for sterilization efforts. Autoclaving at 121°C for 15–20 minutes is typically required to ensure their destruction, whereas many Gram-negative bacteria are eliminated at lower temperatures and shorter durations.
Gram-negative bacteria, lacking spores, employ alternative strategies for environmental survival. One key mechanism is their outer membrane, composed of lipopolysaccharides, which provides resistance to many antibiotics and environmental stressors. Additionally, some Gram-negative species form biofilms—structured communities encased in a protective matrix—that enhance survival in hostile conditions. For example, *Pseudomonas aeruginosa* thrives in hospital settings by forming biofilms on medical devices, resisting desiccation and disinfectants. While biofilms offer protection, they are less durable than spores, making Gram-negative bacteria more vulnerable to prolonged exposure to extreme conditions.
The implications of these survival strategies extend to industries such as food safety and healthcare. Gram-positive spores, like those of *Clostridium perfringens*, can contaminate canned foods, surviving pasteurization processes that would eliminate Gram-negative bacteria. To mitigate this, manufacturers must employ stringent sterilization techniques, such as retorting at 116°C for 30 minutes. Conversely, Gram-negative bacteria like *Escherichia coli* and *Salmonella* rely on rapid replication and biofilm formation to persist in environments like water treatment plants. Here, regular disinfection with chlorine or UV light is effective, as these bacteria lack the resilience of spores.
In summary, spores are a critical survival tool for Gram-positive bacteria, enabling them to endure conditions that would destroy most Gram-negative species. While Gram-negative bacteria compensate with biofilms and robust outer membranes, their survival is more limited in extreme environments. Understanding these differences is essential for developing targeted strategies to control bacterial contamination in various settings, from food production to clinical environments. By recognizing the unique strengths and vulnerabilities of each group, we can more effectively manage the risks they pose.
Are Bamboo Spores Dangerous? Uncovering the Truth and Potential Risks
You may want to see also

Species Examples: *Bacillus* (Gram-positive) vs. *E. coli* (Gram-negative) spore capabilities
Gram-positive and Gram-negative bacteria differ fundamentally in their cell wall structure, but their spore-forming capabilities are equally distinct. Among Gram-positive bacteria, the genus *Bacillus* stands out as a prime example of spore-forming organisms. These spores are highly resistant to extreme conditions, including heat, desiccation, and radiation, making them a survival mechanism par excellence. In contrast, Gram-negative bacteria like *Escherichia coli* (*E. coli*) do not form spores. This distinction is critical in understanding their ecological roles, pathogenicity, and control measures.
Consider *Bacillus anthracis*, the causative agent of anthrax. Its ability to form spores allows it to persist in soil for decades, posing a long-term threat to livestock and humans. Spores of *B. anthracis* can germinate into vegetative cells when ingested or inhaled, leading to infection. To neutralize such spores, autoclaving at 121°C for 15–20 minutes is recommended, as spores are resistant to standard disinfection methods. This highlights the practical implications of spore-forming capabilities in Gram-positive bacteria.
In contrast, *E. coli*, a Gram-negative bacterium commonly found in the human gut, relies on rapid replication and environmental adaptability rather than spore formation. While *E. coli* can survive outside the host for weeks in favorable conditions, it lacks the resilience of *Bacillus* spores. For instance, *E. coli* O157:H7, a pathogenic strain, can be effectively eliminated by cooking food to an internal temperature of 75°C or by using disinfectants like chlorine-based solutions. This underscores the importance of understanding spore absence in Gram-negative bacteria for targeted control strategies.
The spore-forming ability of *Bacillus* species has practical applications in biotechnology, such as the production of enzymes and probiotics. For example, *Bacillus subtilis* spores are used in bioinsecticides and as soil inoculants to promote plant growth. Conversely, the non-spore-forming nature of *E. coli* makes it a preferred host for recombinant DNA technology, as it lacks the complexity of spore-related genes. Researchers often use *E. coli* strains like DH5α for cloning due to their simplicity and ease of manipulation.
In summary, the spore capabilities of *Bacillus* (Gram-positive) versus the non-spore-forming nature of *E. coli* (Gram-negative) illustrate a critical divergence in bacterial survival strategies. While *Bacillus* spores demand rigorous decontamination methods, *E. coli*’s vulnerability to standard treatments simplifies its control. This knowledge is essential for fields ranging from public health to industrial microbiology, where understanding spore formation can dictate the success of interventions and applications.
Can Mold Spores in the Brain Cause Growth and Health Risks?
You may want to see also
Explore related products
$27.25

Cell Wall Structure: Thick peptidoglycan in Gram-positive supports spore development; Gram-negative lacks this
The cell wall is a critical structure in bacteria, determining their classification as Gram-positive or Gram-negative. A key distinction lies in the thickness and composition of peptidoglycan, a polymer that provides structural integrity. Gram-positive bacteria possess a thick peptidoglycan layer, often 20–80 nm, which serves as a robust scaffold for cellular processes, including spore formation. In contrast, Gram-negative bacteria have a thin peptidoglycan layer, approximately 2–3 nm, sandwiched between an inner and outer membrane. This fundamental difference in cell wall architecture directly influences the ability to form spores.
Spore formation, or sporulation, is a survival mechanism employed by certain bacteria to withstand harsh environmental conditions. The thick peptidoglycan layer in Gram-positive bacteria provides a sturdy foundation for the development of spores. During sporulation, the cell wall undergoes significant modifications, including the synthesis of additional layers like the cortex and coat, which are essential for spore resilience. For example, *Bacillus subtilis*, a Gram-positive bacterium, utilizes its thick peptidoglycan layer to support the intricate process of spore assembly, resulting in highly resistant endospores. This structural advantage is absent in Gram-negative bacteria, where the thin peptidoglycan layer and outer membrane complexity hinder spore development.
From a practical standpoint, understanding this cell wall disparity has implications in microbiology and biotechnology. For instance, when culturing bacteria for industrial applications, such as enzyme production or probiotic development, knowing whether a strain is Gram-positive or Gram-negative can predict its potential for sporulation. Gram-positive bacteria like *Clostridium* and *Bacillus* species are commonly exploited for their spore-forming abilities, which enhance product stability and shelf life. In contrast, Gram-negative bacteria, such as *Escherichia coli*, are typically favored for their ease of genetic manipulation but lack the sporulation capacity of their Gram-positive counterparts.
A comparative analysis reveals that the absence of a thick peptidoglycan layer in Gram-negative bacteria is not merely a structural deficiency but a fundamental barrier to spore formation. While Gram-negative bacteria have evolved other survival strategies, such as biofilm formation and antibiotic resistance, they cannot produce spores. This distinction is crucial in clinical settings, where spore-forming Gram-positive pathogens like *Clostridioides difficile* pose unique challenges due to their ability to persist in hostile environments. In contrast, Gram-negative infections, though often more virulent, rely on different mechanisms for survival and transmission.
In summary, the thick peptidoglycan layer in Gram-positive bacteria is a critical enabler of spore development, a trait absent in Gram-negative bacteria due to their thin peptidoglycan and complex membrane structure. This difference has practical implications in biotechnology, industry, and medicine, highlighting the importance of cell wall architecture in bacterial survival strategies. By focusing on this specific aspect of cell wall structure, researchers and practitioners can better predict bacterial behavior and harness their unique capabilities for various applications.
Are All Vascular Plants Spores? Unraveling Plant Reproduction Myths
You may want to see also

Clinical Implications: Spores in Gram-positive increase antibiotic resistance; Gram-negative less affected by spores
Spores, a dormant and highly resistant form of bacteria, are predominantly associated with Gram-positive organisms, particularly those in the *Bacillus* and *Clostridium* genera. This distinction is clinically significant because spore-forming Gram-positive bacteria exhibit heightened resistance to antibiotics, disinfectants, and environmental stressors. For instance, *Clostridioides difficile* spores can survive on hospital surfaces for months, contributing to healthcare-associated infections despite rigorous cleaning protocols. In contrast, Gram-negative bacteria rarely form spores, relying instead on biofilms or intrinsic mechanisms like efflux pumps for survival. This fundamental difference in spore formation has profound implications for infection control, treatment strategies, and antibiotic stewardship.
From a treatment perspective, the presence of spores in Gram-positive bacteria complicates therapeutic approaches. Standard antibiotics, such as beta-lactams or macrolides, are often ineffective against spores due to their impermeable outer coat and dormant metabolic state. For example, *Bacillus anthracis* spores require specific antibiotics like ciprofloxacin or doxycycline, administered at high doses (e.g., 500 mg ciprofloxacin twice daily for adults) and prolonged durations (60 days post-exposure) to ensure eradication. In contrast, Gram-negative infections, such as *Escherichia coli* or *Pseudomonas aeruginosa*, are typically treated with shorter courses of antibiotics, often 7–14 days, as their non-spore-forming nature makes them more susceptible to standard therapies. This disparity underscores the need for tailored treatment protocols based on bacterial morphology.
The clinical challenge intensifies in immunocompromised patients, where spore-forming Gram-positive bacteria pose a heightened risk. For instance, *Clostridium difficile* infections (CDI) are a leading cause of antibiotic-associated diarrhea, with recurrence rates up to 35% due to spore persistence in the gut. Treatment with oral vancomycin (125 mg four times daily for 10–14 days) or fidaxomicin (200 mg twice daily) targets vegetative cells but may fail to eliminate spores, necessitating adjunctive strategies like fecal microbiota transplantation. Conversely, Gram-negative infections in this population, such as *Klebsiella pneumoniae*, are managed with broad-spectrum antibiotics like carbapenems, which remain effective without the added complexity of spore resistance.
Infection control measures must also account for the spore-forming capacity of Gram-positive bacteria. Spores withstand standard alcohol-based hand sanitizers, requiring the use of spore-specific disinfectants like chlorine-based solutions (e.g., 5,000 ppm hypochlorite) for environmental decontamination. This is particularly critical in healthcare settings, where *C. difficile* spores contribute to nosocomial outbreaks. Gram-negative bacteria, lacking spores, are more readily inactivated by routine disinfection protocols, reducing their transmission risk in comparison.
In summary, the presence of spores in Gram-positive bacteria significantly amplifies antibiotic resistance and complicates clinical management, whereas Gram-negative bacteria remain less affected by this phenomenon. Understanding this distinction is essential for optimizing treatment regimens, infection control practices, and patient outcomes. Clinicians must remain vigilant in identifying spore-forming pathogens and employ targeted strategies to address their unique challenges.
Troubleshooting Spore 1004: Resolving Missing Package Errors Effectively
You may want to see also
Frequently asked questions
Yes, many Gram-positive bacteria, such as *Bacillus* and *Clostridium*, are known to form spores as a survival mechanism.
Generally, Gram-negative bacteria do not form spores. However, there are rare exceptions, such as *Adenosynbacter* and *Oceanibacillus*, but these are not typical.
Gram-positive bacteria are more commonly associated with spore formation, as it is a characteristic feature of many species in this group.
Gram-positive bacteria form spores as a survival strategy in harsh conditions, while Gram-negative bacteria often rely on other mechanisms, such as biofilm formation or resistance structures, to endure stress.









![Substances screened for ability to reduce thermal resistance of bacterial spores 1959 [Hardcover]](https://m.media-amazon.com/images/I/51Z99EgARVL._AC_UL320_.jpg)















